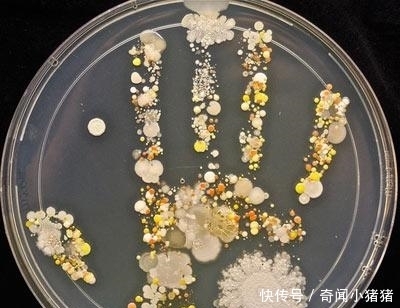
8岁小孩出去玩，回家不洗手按了个手印，妈妈培养48小时后

8岁小孩出去玩,回家不洗手按了个手印,妈妈培养48小时后
我们都知道,人体存在很多的细菌和真菌,只是我们肉眼无法看见,很多家长都教育小孩,在外面玩很脏,回到家里要认真洗手,可是到底有多“脏”,你洗手还是囫囵吞枣吗?下面就让我们见识一下,人身上的细菌长什么样子。下图是一个8岁的熊孩子,出去玩后回来不洗手,生物学家妈妈让孩子在器皿中轻轻按了个手印,然后让这些细菌在合适的环境中培养了48小时,结果出现了这样的景象,这些稀奇古怪颜色怪异的菌落群展现在我们眼前,犹如一幅抽象画,按照孩子手的形状有序的排列着。
文章插图
放在显微镜下仔细观察,这些像黄豆一样的菌落叫做芽孢杆菌,广泛存在我们皮肤上,甚至鼻孔里。这些细菌大多数时候不足以对我们健康造成危害,但是身体抵抗力变差,或者这些葡萄球菌耐药性变强,就会使我们生病。尤其是抵抗力差的儿童!
文章插图
菌落局部照片,像不像沿海地图景观,或者海洋生物,处女座的人应该无法忍受这样的图,可能会感到不适应。
文章插图
这是一小撮外面的感染菌落照片,可能是室内的细菌不小心飘落进来,造型非常独特,在培养皿中细腻圆润,可以作为破案用的线索之一。很多破案高手就是用的这种技术。不过对于我们,这些细菌大多都是无益的,仅有一小部分在体内的细菌是有益的,所以还是越少越好,尽量保持皮肤清洁,尤其是你的小手,洗干净之前不要触摸脸部和食物,以免肤质变差和食物不卫生吃了生病!你有什么想法可以在下方互动,看了这样的图你的感受如何?
【8岁小孩出去玩,回家不洗手按了个手印,妈妈培养48小时后】
文章插图
- 宝宝|18岁女生产下男宝后住宾馆,喂新生儿喝老年奶粉,宝爸去哪了?
- 宝宝|8岁男孩依然在吃母乳,断奶几次都失败告终,对孩子会有影响吗
- 回礼|宝妈母乳太多,每天送给邻居小孩,7天后收到回礼,气得牙痒痒
- 11胞胎|38岁产妇生下11胞胎,七儿四女,产前立下遗嘱先保孩子
- 熙熙|8岁女童从积食拖成脾衰,孩子有3种迹象,脾胃或早已“不堪重负”
- 冰镇|老人常说“小孩无六月”,天再热也别做四件事,做错会让孩子受罪
- 孩子|男孩喝牛奶3年,8岁了却不到1米2:方法没用对,反而耽误长高
- 骨癌|5岁男童患骨癌,背后“元凶”大人小孩都喜欢吃,家长要注意了!
- 宝宝|生完小孩后,医生如果再次把手伸进产道,可能是在救产妇
- 王女士|中国首例“5胞胎”,如今均满18岁,他们的家庭状况怎么样?
